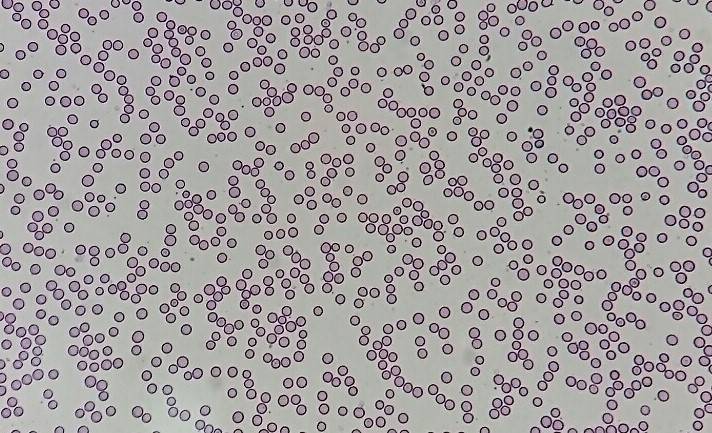
写真③.jpg
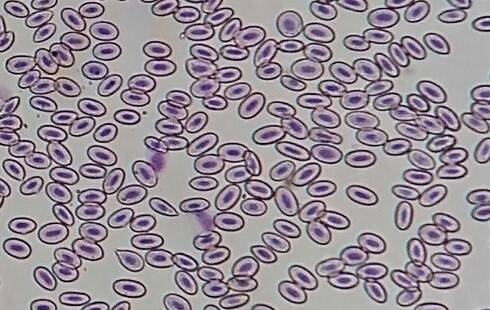
写真④.jpg

更新日:2021.05.20こんな所にもある動物の違い
更新日:2021.05.20
こんな所にもある動物の違い
健康診断に行くと、採血をしますよね。

みなさんも体調が悪くなった際に、病院で血液検査をすることがあるかと思います。同じように、動物園でも血液検査をします。
検査の1つとして、血液の成分を顕微鏡で観察するものがあります。みなさん、赤血球はご存じですか? 血液の中で酸素を運ぶ大切な役割をしています。
こちらはカンガルーの血液を顕微鏡で見たもので、小さな丸いものが赤血球です。どれくらいの数の赤血球が血液の中に含まれているかを計算します。

検査では、分かりやすいように血球を染色してから観察もしており、赤血球を染色するとこの様に赤っぽく見えます。ちなみにこちらはオオツノヒツジの赤血球です。
では、これは何でしょうか?
ここまでご紹介した写真とだいぶ違います。実はこれも赤血球(染色したもの。他の血球も少し混じっています)。これはフクロウの赤血球です。
鳥類の赤血球は、哺乳類である私たちヒトや、カンガルー、オオツノヒツジ等とだいぶ違います。
専門的なことを言うと、哺乳類の赤血球はできあがる途中で核がなくなるのですが、鳥の赤血球では核が残ります。(写真の赤血球の中心にある色が濃くなっている部分が核です)
動物って色々違っておもしろいですよね。
(獣医 かみて)